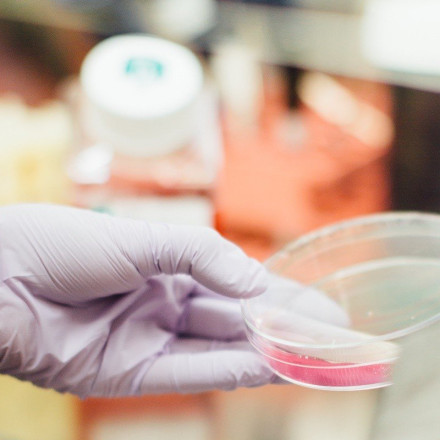
Ημαθία: Θετικά στον στρεπτόκοκκο 7 παιδιά στη Νάουσα - Μόνο 2 με συμπτώματα - Έγιναν 45 τεστ

Από Πάτρα μέχρι Ρέθυμνο: Πόσο κοστίζει τελικά το αποκριάτικο τριήμερο
Οι Απόκριες φέρνουν γεμάτα καταλύματα και «τσιμπημένες» τιμές. Από την Πάτρα και τη Νάουσα έως το Ρέθυμνο, οι πληρότητες εκτοξεύονται και το κόστος για το τριήμερο ανεβαίνει αισθητά.